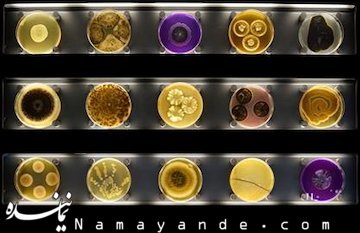
بهجای پاندا ویروس ابولا را از نزدیک ببینید! ابولا

به گزارش نماینده به نقل از مهر، باغ وحش همواره یادآور حیواناتی مانند شیر، پلنگ، آهو، خرس و ... است اما روز گذشته باغ وحش متفاوتی در آمستردام افتتاح شد تا موجودات متفاوتی را به نمایش بگذارد. در این باغ وحش، ویروس ها و باکتری و قارچ جایگزین پاندا و شیر شده اند تا نام اولین باغ وحش متفاوت دنیا را به خود اختصاص داده باشند. این باغ وحش با هزینه ای بیش از ۱۰ میلیون یورو و در مدت یازده سال تاسیس شده است.
مدیر این باغ وحش در مصاحبه ای در روز افتتاحیه گفت: "حیواناتی مانند شیر، ببر و غیره را در مستندات تلویزیونی یا باغ وحش ها دیده ایم اما سایر موجوداتی که ذره بینی هستند و کمتر به آنها پرداخته می شود نیز از اهمیت بالایی برخوردار هستند اما کمتر کسی آنها را دیده است. امروز ما در این باغ وحش میکروسکوپی به آنها پرداخته ایم. زیرا تنها اسامی این موجودات را در زمان ابتلا به بیماری می شنویم و از ماهیت آنها کمتر آگاهیم. "
وی در ادامه افزود:"در زندگی امروز، میکرو ارگانیسم ها دارای اهمیت مضاعفی هستند و نقش مثال زدنی را در زندگی و همینطور پیشرفت علم و کشاورزی ایفا می کنند. می توان گفت این موزه همانند یک آزمایشگاه زنده است با این تفاوت که در آزمایشگاه ورود عموم آزاد نیست اما در این باغ وحش به روی عموم باز است. از سوی دیگر، بازدید کنندگان این موزه قادر به دیدن تغییر و تحولات ویروس ها و تبدیل آنها به ویروس های مرگباری مانند"ابولا" نیز خواهند بود. "
یکی دیگر از شگفتی های قابل توجهی که در این باغ وحش صورت می گیرد، نمایش فعالیت های زیستی بدن بازدیدکنندگان بر پلتفرم های بزرگی است که تعجب و شگفتی مراجعه کنندگان را برانگیخته است.

نظر شما